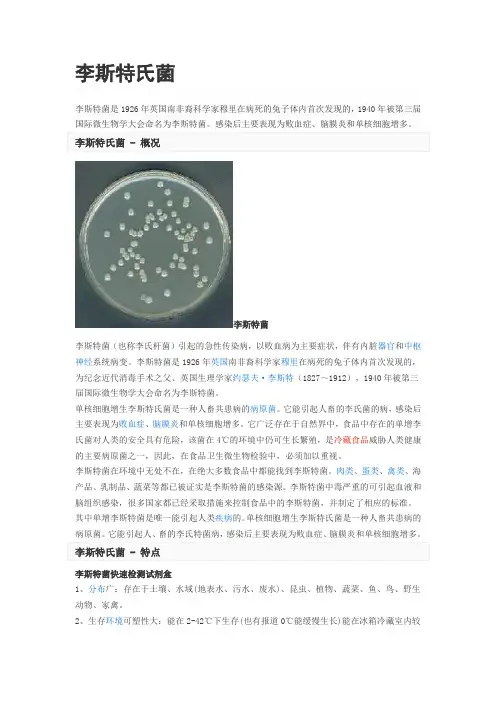

单核细胞增生李斯特菌脑膜炎1例
- 格式:pdf
- 大小:881.46 KB
- 文档页数:3




去泛素化酶ABRO1对李斯特菌感染单核巨噬细胞IL -1β释放的影响及其机制王琳1,穆红1,申艳娜21 天津市第一中心医院检验科,天津300192;2 天津医科大学医学检验学院摘要:目的 观察去泛素化酶Abraxas 兄弟蛋白(ABRO1)对李斯特菌(LM )感染的小鼠单核巨噬细胞J774A.1白细胞介素(IL )-1β释放的影响,并探讨相关机制。
方法 培养J774A.1细胞,分别感染有李斯特菌溶血素O (LLO )的野生型LM 菌株(野生型组)、敲除LLO 的hly 基因缺失(Δhly )LM 菌株(基因缺失组)及Δhly 株回补hly 基因的LM 菌株(回补株组),采用Western blotting 法检测ABRO1蛋白,ELISA 法检测细胞培养液上清中的IL -1β。
将J774A.1细胞分为NI 组(未感染LM 菌株)、WT 组(感染WT LM 菌株)与Δhly 组(感染Δhly LM 菌株),各组分别转染NC siRNA 、ABRO1 siRNA ,采用ELISA 法检测细胞培养液上清中的IL -1β,采用Western blotting 法检测炎症小体相关分子Caspase -1、p20(Caspase -1活化形式)、IL -1β、p17。
结果 随着感染时间延长,野生型组、回补株组ABRO1表达、IL -1β水平逐渐增高,在感染120 min 达到最高、均高于基因缺失组(P 均<0.05);基因缺失组不同时点ABRO1表达、IL -1β水平无明显变化。
WT 组转染ABRO1 siRNA 的细胞培养液上清中IL -1β水平及p20、p17表达低于转染NC siRNA 的细胞(P 均<0.05);WT 组转染NC siRNA 的细胞培养液上清中IL -1β水平及p20、p17表达高于NI 组(P 均<0.05);Δhly 组转染NC siRNA 的细胞培养液上清中IL -1β水平及p20、p17表达低于WT 组(P 均<0.05)。




食品中单核细胞增生性李斯特氏菌的检测方法摘要:通过扩增hly 基因建立检测单核细胞增生性李斯特氏菌(Lm)的PCR 方法。
该方法具有较强的特异性,35株经传统方法鉴定的菌株PCR 结果均为阳性,而其他三种同属异种菌,包括英诺克李斯特氏菌、绵羊李斯特氏菌和威尔斯李斯特氏菌及非李斯特氏菌均未扩增出特异性的片段。
PCR 方法对Lm 纯培养物的最低检测限为7.3CFU/μl,对模拟污染的生猪肉和蔬菜的检测低限为4CFU/g,牛奶为4CFU/ml。
应用该方法对285 份食品样品检测,17 份样品Lm 呈阳性,结果与常规的分离培养方法完全一致。
该种方法具有敏感、特异、快速及准的优点,可用于食品中L m 的快速检测。
关键词:食品;单核细胞增生性李斯特氏菌;聚合酶链式反应Abstract :A polymerase chain reaction (PCR) assay targeting the hly gene was developed to detect Listeria monocytogenes.The PCR product was detected in 35 L monocytogenes strains and not in other Listeria spp, including innocua, ivanovii andwelshimer and also not in non-Listeria species, indicating that this method was highly specific for L. monocytogenes. The detectionlimit of the PCR assay was 7.3 CFU/μl o f pure cell culture. The PCR assay could detect4 CFU of L. monocytogenes in thecontaminated pork and vegetable (1g) and milk (1ml). From 285 samples, 17 samples were proved positivefor L. monocytogenesby the PCR method, and the results were quite consisted with those detected by conventional biochemical testing. The PCRassay is highly sensitive, specific, rapid and accurate and can be used for rapid detection of L. monocytogenes in food.Key words:food;Listeria monocytogenes;PCR;detection1引言1.1李斯特氏菌-概况李斯特菌(也称李氏杆菌)引起的急性传染病,以败血病为主要症状,伴有内脏器官和中枢神经系统病变。
李斯特氏菌李斯特菌是1926年英国南非裔科学家穆里在病死的兔子体内首次发现的,1940年被第三届国际微生物学大会命名为李斯特菌。
感染后主要表现为败血症、脑膜炎和单核细胞增多。
李斯特氏菌 - 概况李斯特菌李斯特菌(也称李氏杆菌)引起的急性传染病,以败血病为主要症状,伴有内脏器官和中枢神经系统病变。
李斯特菌是1926年英国南非裔科学家穆里在病死的兔子体内首次发现的,为纪念近代消毒手术之父、英国生理学家约瑟夫·李斯特(1827~1912),1940年被第三届国际微生物学大会命名为李斯特菌。
单核细胞增生李斯特氏菌是一种人畜共患病的病原菌。
它能引起人畜的李氏菌的病,感染后主要表现为败血症、脑膜炎和单核细胞增多。
它广泛存在于自然界中,食品中存在的单增李氏菌对人类的安全具有危险,该菌在4℃的环境中仍可生长繁殖,是冷藏食品威胁人类健康的主要病原菌之一,因此,在食品卫生微生物检验中,必须加以重视。
李斯特菌在环境中无处不在,在绝大多数食品中都能找到李斯特菌。
肉类、蛋类、禽类、海产品、乳制品、蔬菜等都已被证实是李斯特菌的感染源。
李斯特菌中毒严重的可引起血液和脑组织感染,很多国家都已经采取措施来控制食品中的李斯特菌,并制定了相应的标准。
其中单增李斯特菌是唯一能引起人类疾病的。
单核细胞增生李斯特氏菌是一种人畜共患病的病原菌。
它能引起人、畜的李氏特菌病,感染后主要表现为败血症、脑膜炎和单核细胞增多。
李斯特氏菌 - 特点李斯特菌快速检测试剂盒1、分布广:存在于土壤、水域(地表水、污水、废水)、昆虫、植物、蔬菜、鱼、鸟、野生动物、家禽。
2、生存环境可塑性大:能在2-42℃下生存(也有报道0℃能缓慢生长)能在冰箱冷藏室内较长时间生长繁殖。
3、适应范围大:酸性、碱性条件下都适应。
4、带菌较高的食品有:牛奶和乳制品;肉类(特别是牛肉);蔬菜;沙拉;海产品;冰淇凌等。
李斯特氏菌 - 生存环境单核细胞李斯特菌在半固体培养基上生长情况李斯特菌具有较强的反抗力,秋冬时期在土壤中能存活5个月以上,在冰块内也可存活3~5个月,许多冷冻肉类都是它的“温床”。

食品中单核细胞增生李斯特氏菌检测方法的探讨张慧珍(谱尼测试集团股份有限公司,北京 100194)摘 要:单核细胞增生李斯特氏菌(Listeria monocytogenes)是一种人畜共患病的病原菌,是一种常见的土壤细菌,能引起严重食物中毒,感染后主要表现为败血症、脑膜炎和单核细胞增多。
单核细胞增生李斯特氏菌广泛存在于自然界中,食品中存在的单核细胞增生李斯特氏菌对人类的安全具有一定的威胁,该菌在4 ℃的环境中仍可生长繁殖,是冷藏食品中威胁人类健康的主要病原菌之一。
本文通过采用国家标准检测方法《食品安全国家标准食品微生物学检验单核细胞增生李斯特氏菌检验》(GB 4789.30—2016)对大量肉、奶、蛋和水产品等产品中单核细胞增生李斯特氏菌的检测,总结了一些食品中单核细胞增生李斯特氏菌的检测经验,主要从试剂准备、增菌、划线分离及生化鉴定等方面阐述了对单核细胞增生李斯特检测的一些理解,以期为食品检测工作中单核细胞增生李斯特氏菌的检测提供部分参考。
关键词:食品;单核细胞增生李斯特氏菌;国标检测方法Discussion on Detection Method of Listeria monocytogenes in FoodZHANG Huizhen(Pony Testing Group International Co., Ltd., Beijing 100194, China) Abstract:Listeria monocytogenes is a zoonotic pathogen. It is a common soil bacterium that can cause serious food poisoning. After infection, it is mainly manifested in sepsis, meningitis and mononucleosis. It exists widely exists in nature. Listeria monocytogenes in food is dangerous to human safety. The bacteria can still grow and reproduce in the environment of 4 ℃, and it is one of the main pathogenic bacteria that threaten human health in refrigerated food. By using the national standard detection method GB 4789.30—2016 to detect Listeria monocytogenes in a large number of meat, milk, eggs and aquatic products, this paper summarizes the detection experience of Listeria monocytogenes in some foods, and expounds some understandings of Listeria monocytogenes detection mainly from the aspects of reagent preparation, enrichment, lineation separation and biochemical identification, in order to provide some reference for the detection of Listeria monocytogenes in food testing.Keywords: food; Listeria monocytogenes; national standard detection method李斯特氏菌属隶属革兰氏阳性细菌中厚壁菌门,李斯特氏菌属可划分为6个菌种,即单核增生李斯特氏菌(L. monocytogenes)、英诺克李斯特氏菌(L. innocua)、斯氏李斯特氏菌(L. seeligeri)、威尔斯特氏菌(L. welshimeri)、伊氏李斯特菌(L. ivanovii)和格氏李斯特菌(L. grayi)[1]。

妊娠期感染单核李斯特菌的2例报告及文献回顾
李永红;王佩华;靳文亮
【期刊名称】《继续医学教育》
【年(卷),期】2022(36)6
【摘要】目的分析孕妇感染单核细胞增生李斯特菌(Listeria monocytogenes,LM)的临床特点和预后,为临床提供相应指导。
方法选择2例2021年8月和2022年1月感染李斯特菌病的孕妇,对其临床病例资料给予分析,包括孕妇的一般情况、临床症状、抗菌药物治疗经过和护理管理方面,以及胎儿的结局转归。
结果2例孕妇感染LM发生在妊娠晚期,孕周为33~37周,住院时均发热,其中一例已产生宫缩;1例顺产1活婴,1例剖宫产1死婴。
结论孕妇感染LM的临床表现不典型,伴有发热,表现为流感样症状,胎动异常。
该病菌感染对孕妇危害不大但易造成胎儿死亡,主要采用抗生素药物治疗,产科医护工作者必须对感染李斯特菌的孕妇提高警惕,做到早发现、早诊断、早治疗,从而改善母婴结局。
【总页数】4页(P121-124)
【作者】李永红;王佩华;靳文亮
【作者单位】天津市静海区医院产科;天津市静海区医院公共卫生科
【正文语种】中文
【中图分类】R714
【相关文献】
1.单核细胞增多性李斯特菌脑膜炎1例报告并文献回顾
2.妊娠期产单核李斯特菌感染2例
3.妊娠期单核细胞增多性李斯特菌感染及对母儿的影响
4.妊娠晚期孕妇感染产单核李斯特菌致胎死宫内2例报告并文献回顾
5.妊娠期单核细胞增生李斯特菌感染孕妇临床特点分析
因版权原因,仅展示原文概要,查看原文内容请购买。
单增李斯特菌的调查报告一、单增李斯特菌的概述生活中李斯特菌到处存在,但其中只有一种为致病菌。
李斯特菌可从各种食品样本中分离出来包括乳制品、肉类、蔬菜和海鲜,也可从食品加工过程中的环境中分离而来。
李斯特菌中毒严重的可引起血液和脑组织感染,很多国家都已经采取措施来控制食品中的李斯特菌,并制定了相应的标准。
目前国际上公认的李斯特菌共有七个菌株:(1)单核细胞增生李斯特菌 (Listeria monocytogenes/L.mono)(2)绵羊李斯特菌 (Listeria iuanuii)(3)英诺克李斯特菌(Listeria innocua)(4)威尔斯李斯特菌(Listeria welshimeri)(5)西尔李斯特菌 (Listeria seeligeri)(6)格氏李斯特菌 (Listeria grayi)(7)默氏李斯特菌 (Listeria murrayi)其中单增李斯特菌(Listeria monocytogenes/L.mono)是唯一能引起人类疾病的。
单核细胞增生李斯特氏菌是一种人畜共患病的病原菌。
它能引起人、畜的李氏特菌病,感染后主要表现为败血症、脑膜炎和单核细胞增多。
它广泛存在于自然界中,食品中存在的单增李氏菌对人类的安全具有危险,该菌在4℃的环境中仍可生长繁殖,是冷藏食品威胁人类健康的主要病原菌之一。
在美国LM被列为7种主要的食源性致死病菌之一,已经被WHO食品安全工作计划列为重点检测的食源性病原菌之一。
LM为需氧或兼性厌氧菌,生长温度为1~45℃,对不利环境具有较强的耐受能力,在4℃冰箱中也可生长繁殖,在pH 5.0~9.0的环境中, 1年后仍可检出,这使其危害性进一步增大。
另外,LM病原体定居在细胞内,因此应用抗生素治疗效果不理想。
由于LM引起的疾病及其食源性感染日益引起世界各国的重视,对该病建立快速、灵敏、准确的检测是有效防治本病、诊断病原菌和保证食品卫生安全的重要手段。
二、单增李斯特菌的检测方法(1)平板培养法(国标):用不同浓度的沙门菌菌悬液人工染菌二类食品各4o份,用增菌液两步增菌,两种分离培养基分离,对比检出率及分离效果。
中国感染与化疗杂志2015年3月20日第15卷第2期Chin J Infect Chemother,Mar.2015,Vo1.15,No.2 179 除手术,且患者有长期大量饮酒史,可能是导致患者发生急 性单核细胞增生李斯特菌感染的重要诱因 2]。 成人社区获得性细菌性脑膜炎中,李斯特菌脑膜炎约为 16.5 [1]。本例患者在急性细菌性脑膜炎的基础上并发脑
梗死m 。 本例患者为高龄患者,且患者颈部血管超声检查提示有 动脉粥样硬化斑块形成,上述因素亦可能是导致患者脑梗死 发生的重要危险因素 。 李斯特菌脑膜炎在明确诊断之前,大多数患者均给予经 验性的抗感染治疗。本例患者在明确诊断前给予头孢曲松 抗感染治疗,但疗效差。研究显示,第三代头孢菌素对单核 细胞增生李斯特菌的抗菌活性弱,因而不宜选择该类药物治 疗李斯特菌脑膜炎[6]。青霉素或氨苄西林是李斯特菌脑膜 炎的首选治疗药物l7],氨苄西林作为李斯特菌脑膜炎的首选 药物,其疗效和安全性已得到公认。本例患者根据药敏试验 结果选用美洛西林抗感染治疗后,症状及体征亦得到改善, 治疗有效。而对于青霉素类药物过敏的患者,可选用甲氧苄 啶一磺胺甲嚅唑、利福平、万古霉素、红霉素等药物治疗,上述 药物对李斯特菌脑膜炎亦有一定的疗效 j。 李斯特菌脑膜炎病情危重,常发生于免疫功能较差,伴 有基础疾病的患者,病死率高。临床上应提高对该病的认 识,早期诊断和给予针对性的抗感染治疗至关重要。
参考文献: [1]Amaya—Villar R,Garcia—Cabrera E,Sulleiro—Igual E,et a1.
Three—year multicenter surveillance of community-acquired Listeria monocytogenes meningitis in adults[J].BMC Infect Dis,2010,10:324. C,oulet V,Hebert M,Hedberg C,et a1.Incidence of 1isteriosis and related mortality among groups at risk of acquiring listeriosis EJ2.Clin Infect Dis,2012,54(5):652 660. Katchanov J,Heuschmann PU,Endres M,et a1.Cerebral infarction in bacterial meningitis:predictive factors and outcomel-J].J Neurol,2010,257(5):716 720. schut ES,Lucas MJ,Brouwer MC,et a1.Cerebral infarction in adults with bacterial meningitis[J].Neurocrit Care,2012, I6(3):421—427. Grau AJ,Weimar C,Buggle F,et a1.Risk factors, outcome,and treatment in subtypes of ischemic stroke:the German stroke data bankIJ].Stroke,2001,32(11):2559— 2566. Tunkel AR,Wispelwey B,Scheld WM.Bacterial meningitis: recent advances in pathophysiology and treatment I-J]. Ann
·病例报告·作者单位:1. 天津南开医院,中西医结合医院脑病科,天津 300100;2. 天津市人民医院。
作者简介: 李佳(1978—),女,博士研究生,主治医师,从事中西医结合脑病临床诊治。
通信作者:田卓民,E-mail :tianzhuomin19@ 。
单核细胞增生李斯特菌脑膜炎1例李 佳1, 田卓民2关键词: 单核细胞增生李斯特菌; 脑膜炎; 感染中图分类号:R512.3 文献标识码:D 文章编号:1009-7708 ( 2018 ) 02-0206-03DOI: 10.16718/j.1009-7708.2018.02.015Listeria monocytogenes meningitis: one case reportLI Jia, TIAN Zhuomin. (Department of Traditional Chinese Medicine and Neurology, Tianjin Nankai Hospital, Tianjin 300100, China )1 临床资料患者男,80岁,退休干部。
既往体健,于2015年6月7日因剧烈头痛,神志恍惚入院。
入院前1 d ,开始发热伴头痛,自以为“感冒”,服“布洛芬”,体温暂时降至正常后复升达40.5 ℃。
入院当天查体:T 39.0 ℃,P 100次/m in ,R 20次/min ,BP 150/90 mmHg ,神志恍惚,言语欠流利,颈项强直,四肢肌力Ⅳ级,肌张力正常,腱反射(++),Kernig 征(+),双侧巴氏征(-),双侧指鼻试验、轮替试验及跟膝胫试验欠合作。
外周血白细胞14.0×109/L ,中性粒细胞比例0.925;血沉 24.0 mm/h ,肝肾功能正常。
6月8日腰穿初压266 mmH 2O ,末压159 mmH 2O ,脑脊液(CSF )外观无色透明,白细胞355×106/ L ,葡萄糖 1.41 mmol/L ,氯化物106.0 mmol/ L ,蛋白 3.63 g/ L 。
在细菌学结果尚未回报的情况下,治疗方案:甘油果糖250 mL ,每8小时1次静脉滴注,哌拉西林-他唑巴坦钠静脉输注,联合异烟肼、利福平、乙胺丁醇口服;地塞米松静脉注射。
3 d 后(6月11日),意识障碍加重,嗜睡,仍发热,体温达39.8 ℃,外周血白细胞12.4×109/ L ,中性细胞比例0.874 ,当日CSF 与血细菌培养回报均为“单核细胞增生李斯特菌(Listeria monocytogenes )” ,CSF 细菌涂片阴性,抗酸染色(-)、墨汁染色(-), 结核抗体(-)。
将治疗方案更改为氨苄西林2 g ,每6小时1次静脉滴注,继续甘油果糖治疗。
同时进行第2次腰穿,初压179 mmH 2O , 末压99 mmH 2O ,CSF 外观无色透明,白细胞计数295×106/L ,葡萄糖 2.98 mmol/ L ,氯化物108.9 mmol/L ,蛋白1.84 g/ L 。
第2次腰穿CSF 和血培养回报仍为单核细胞增生李斯特菌。
而CSF 细菌涂片阴性、抗酸染色、墨汁染色均(-),CSF 结核抗体(-)。
氨苄西林治疗4 d 后,患者神志完全转清,但语言欠流利,体温37.4 ℃,外周血白细胞8.30×109/L ,中性细胞比例0.672。
入院第10天,体温及生命体征正常。
住院期间共做7次腰穿,自第3次腰穿开始,CSF 压力正常,常规和生化结果逐步趋于正常,连续3次(第 3、4、5次)CSF 和血细菌培养结果均为阴性。
氨苄西林静脉滴注3周,氨苄西林胶囊口服4周后痊愈出院。
2 讨论1924年Murray 发现第1例单核细胞增生李斯特菌病(Listeria monocytogenes disease )[1],已报道的该病主要发生在欧美发达国家,而亚洲、非洲及南美洲等发展中国家很少见。
单核细胞增生李斯特菌是李斯特菌属中现有的2个群7个种之一的短小革兰阳性无芽胞杆菌。
该菌生长在广泛的自然环境中,最适宜生长温度30~37 ℃,可在冰箱贮存的多种食品中繁殖,是典型的耐寒性细菌,亦为食源性致病菌。
主要存在于冷藏肉类制品、乳产品、海鲜以及蔬菜水果中。
能使人和哺乳动物致病,并引起血流感染及神经系统感染,病死率较高。
近年,欧美国家常有关于单核细胞增生李斯特菌食物中毒事件的报道,我国相关报道较少。
人体感染单核细胞增生李斯特菌通常是通过胃肠道食入污染的食物。
虽然本病可能暴发,但以散发为主。
据近年来美国CDC的统计数据,美国的人群发病率为2/百万~9/百万,1989-1993年的年发病率已降低了44%,此与严格的食品法规有关。
近年的发病率为3/百万[2]。
到目前为止,我国尚无准确的发病率报道,但有资料认为1个月以下幼儿及60岁以上的老人发病率最高[3]。
单核细胞增生李斯特菌系胞内致病菌,不产生内毒素,可产生β溶血素,是该菌的主要毒力因子之一。
无流行病学资料或临床证据支持人与人之间传染,受感染的患者也不需要隔离。
可以有垂直传播即母亲传给胎儿。
人体对单核细胞增生李斯特菌的免疫属于细胞免疫。
单核细胞增生李斯特菌进入人体血循环后可播散至任何部位,但是更趋向于中枢神经系统。
也有较少见的情况,即该菌在轴索内经脑神经到达中枢神经系统。
成人感染该菌主要表现为各种脏器的实质性病变,包括胃肠炎(多见于暴发流行)、心内膜炎、血流感染、脑膜炎和中枢神经系统的局灶性感染,其中,脑膜炎最常见。
有报道称,在美国单核细胞增生李斯特菌脑膜炎占所有成人社区获得性细菌性脑膜炎的5%~10%,病死率为15%~26%,而且不随时间推移有所改变[4]。
关于单核细胞增生李斯特菌脑膜炎的诊断,除根据病史及临床表现外,最重要的依据是CSF 细菌培养[5],但是在得到CSF培养阳性结果之前,很难作出针对单核细胞增生李斯特菌脑膜炎的治疗决定。
腰穿压力增高,CSF细胞学检查显示白细胞计数增高,生化检查蛋白定量增高、葡萄糖降低、氯化物降低,只提示符合化脓性感染,此时需要鉴别的还包括常见的脑膜炎双球菌、肺炎球菌和流感嗜血杆菌脑膜炎等。
此外,结核性脑膜炎(非化脓性炎症)CSF的细胞学表现几乎与之相似,此时结合临床并等待培养结果,有助于鉴别。
尽管本例患者的现病史不存在可以怀疑单核细胞增生李斯特菌感染的某些情况如血液恶性肿瘤、AIDS、器官移植以及应用皮质激素等,但该患者高龄同时具有急性脑膜炎的临床表现,在我们接诊的第1天即警惕该菌感染的可能性。
住院后第3天,CSF和血培养均回报单核细胞增生李斯特菌阳性,且CSF常规生化基本符合化脓性感染,因此确定了单核细胞增生李斯特菌脑膜炎的诊断。
此外,及时与临床细菌室人员沟通,特别提醒留意该菌的可能,尤其对于这类少见细菌经验不多的实验员来说也很关键。
在判断培养结果方面,要警惕单核细胞增生李斯特菌可能被误认为类白喉杆菌、链球菌、肠球菌或流感嗜血杆菌[6]。
应强调2种情况须谨慎对待:①不要随意将初见的革兰阳性杆菌误判为标本污染;②初次培养出革兰阴性杆菌后,转血平皿再培养,结果为革兰阳性杆菌的情况[7]。
当单核细胞增生李斯特菌胃肠炎暴发流行而常规粪便培养结果阴性时,推荐作特殊粪便培养。
单核细胞增生李斯特菌可以在许多不发病的人肠道中定植。
另外,为排除污染菌血培养标本应送检双份,即左、右手2个部位采血,中间间隔半小时;同时送CSF细菌培养[8]。
本例CSF和血培养送检后3 d即回报单核细胞增生李斯特菌阳性。
单核细胞增生李斯特菌脑膜炎治疗包括脑膜炎的一般治疗和针对病原的抗生素选择。
本例在甘油果糖脱水降颅内压以及其他支持治疗基础上,抗生素的选择在CSF培养结果回报前,应用哌拉西林-他唑巴坦钠联合抗结核药物,是基于对多种病原菌的覆盖,如较常见的脑膜炎双球菌、肺炎链球菌和流感嗜血杆菌,以及在不能排除结核性脑膜炎时联合抗结核药物治疗,类似病例时有报道[9]。
确诊单核细胞增生李斯特菌脑膜炎后,立即改用氨苄西林作为首选药物。
此外,首选大剂量青霉素,以及青霉素与氨基糖苷类联合具有协同作用。
青霉素过敏者可选用甲氧苄啶-磺胺甲唑。
单核细胞增生李斯特菌脑膜炎的抗生素治疗疗程应不少于3周,而脑脓肿需6周以上[10],本例仅以氨苄西林单药,剂量为2 g,每6小时1 次,日用量8 g,4 d后,神志完全转清,体温降至37.4 ℃,外周血白细胞降至8.30×109/L,中性粒细胞比例0.672;腰穿压力逐渐下降,CSF常规、生化检查结果均逐渐趋于正常。
本例总疗程7周。
参考文献[1] THIGPEN MC, WHITNEY CG, MESSONNIER NE, et a1.Bacterial meningitis in the United States,1998-2007[J]. N Engl J Med,2011,364(21):2016-2025.[2] LORBER B. Listeria monocytogenes[M]//MANDELL GL,BENNETT JE, DOLIN R. Principles and practice of infectious diseases. 6th ed. Philadelphia: Churchill Livingstone, 2005:2478-2484.[3] KASPER DL,FAUCI AS, LONGO DL. Harrison's principles ofinternal medicine [M]. 18ed. Mc Graw Hill, 2005:1194-1195. [4] WYNGAARDEN JB,SMITH LH. Cecil text book of medicine[M]. 24ed. WB Suaders, 2012:1835-1837.[5] DOGANAY M. Listeriosis:clinical presentation[J]. FEMSImmunol Med Microbiol,2003,35(3):173-175.[6] AMAYA-VILLAR R, GARCIA-CABRERA E, SULLEIRO-IGUAL E, et al. Three- year multicenter surveillance of community acquired Listeria monocytogenes meningitis in adults[J]. BMC Infect Dis, 2010,10(11):324-331. [7] CUNHA BA, FATEHPURIA R, EISENSTEIN LE. Listeriamonocytogenes encephalitis mimicking Herpes Simplex virus encephalitis:the differential diagnostic importance of cerebrospinal fluid lactic acid levels[J]. Heart Lung,2007,36(3):226-231.[8] MYLONAKIS E, HOHMAILN EL, CALDERWOOD SB.Central nervous system infection with Listeria monocytogenes:33 years’experience at a general hospital and review of 776episodes from the literature[J]. Medicine(Baltimore),1998,77(5):313-336.[9] 刘袁媛,张文宏,王冯滨. 重症单核细胞增多性李斯特菌脑膜脑炎1例[J]. 微生物与感染,2011,6(3):153-157. [10] BECKHAM JD, TYLER KL,IDSA. Initial managementof acute bacterial meningitis in adults:summary of IDSA guidelines[J]. Rev Neurol Dis,2006,3(2):57-60.[11] VIALE P, FURLANUT M, CRISTINI F, et al. Major role oflevofloxacin in the treatment of a case of Listeria monocytogenes meningitis[J]. Diagn Microbiol Infect Dis,2007,58(1):137-139.收稿日期:2017-06-02 修回日期:2017-06-29WHO:也门感染霍乱病例数骤增,死亡人数增多Yemen cholera caseload leaps, death toll rises: WHO·信息交流·2017年5月23日【路透社(汤姆迈尔斯)】:世界卫生组织(WHO)的一份报告显示,自4月27日也门霍乱疫情快速蔓延以来,霍乱病例数急剧增加,目前已发现35 217例疑似病例,与5月19日也门WHO发言人Nevio Zagaria公布的23 425例相比增加了50%。